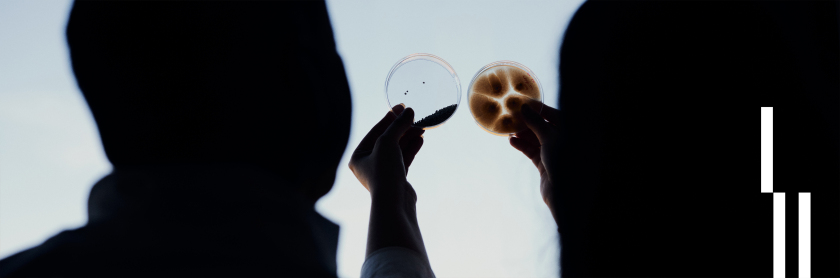
A researcher holds petri dishes

- Home
-
Hochschule
- Aktuelles
-
Profil
- Zahlen, Daten, Fakten
- Selbstverständnis der HSBI
- Qualitätsverständnis
- Leitbild Lehre
- Lehrpreis
- Netzwerk Innovatives Lehren und Lernen (InnoLL)
- Prozessmanagement
- Familiengerechte Hochschule
- Diversity
- Weltoffene Hochschule
- Strategie Internationales
- Nachhaltigkeit
- Rückblick: 50 Jahre FH Bielefeld
- Feedback
- Fachbereiche
- Zentrale Organisation
- Standorte / Anfahrt
- HSBI-Portale
-
Studium
- Studienangebote
-
Beratung
- Studienorientierung
- Zentrale Studienberatung
- Studienfachberatung
- Psychosoziale Beratung
- Studienfinanzierung und Stipendien
- Schreibberatung
- Studieren mit beruflicher Qualifikation
- Studieren mit ausländischen Zeugnissen
- Studieren mit Handicap
- Studieren mit Familie
- Informationen für Schulen
- Auslandsaufenthalt
-
Bewerbung
- Auswahlgrenzen und Vergabeverfahren (NC)
- Bewerbungsportal
- Bewerbung Schritt für Schritt: Von der Bewerbung bis zur Einschreibung
- Bewerbung für ein höheres Fachsemester
- Bewerbung mit beruflicher Qualifikation
- Jungstudierende
- Gasthörerschaft und Zweithörerschaft
- Kontakt Studierendenservice
- Losverfahren
- Promotion
- Sonderanträge
- Studiengang wählen
- Wer kann an der HSBI studieren?
- Studienstart
-
Studium organisieren
- Studierendenservice
- Abschlussunterlagen
- Anerkennung von Leistungen
- Anträge einreichen
- Beurlaubung
- CampusCard
- Einreichung schriftliche Arbeiten
- Erstattung
- Exmatrikulation
- IT-Services
- Online-Serviceportale (LSF/CAT)
- Prüfungsangelegenheiten: Ordnungen, Modulhandbücher
- Rücktritt von einer Modulprüfung
- Rückmeldung
- Semesterbeitrag
- Semesterticket (Deutschlandsemesterticket)
- Semester-, Vorlesungs- und Prüfungszeiten
- Studienbezogene Auslandserfahrung
- Vorlesungsverzeichnis
- Rund ums Studium
- Fachbereiche
- Forschung
- Transfer
- Weiterbildung
- Internationales
- Karriere an der HSBI
Hochschule Bielefeld University of Applied Sciences and Arts
- Hochschule
- Hochschule
- Aktuelles
-
Profil
- Zahlen, Daten, Fakten
- Selbstverständnis der HSBI
- Qualitätsverständnis
- Leitbild Lehre
- Lehrpreis
- Netzwerk Innovatives Lehren und Lernen (InnoLL)
- Prozessmanagement
- Familiengerechte Hochschule
- Diversity
- Weltoffene Hochschule
- Strategie Internationales
- Nachhaltigkeit
- Rückblick: 50 Jahre FH Bielefeld
- Feedback
- Fachbereiche
- Zentrale Organisation
- Standorte / Anfahrt
- HSBI-Portale
- ×
- Studium
- Studium
- Studienangebote
-
Beratung
- Studienorientierung
- Zentrale Studienberatung
- Studienfachberatung
- Psychosoziale Beratung
- Studienfinanzierung und Stipendien
- Schreibberatung
- Studieren mit beruflicher Qualifikation
- Studieren mit ausländischen Zeugnissen
- Studieren mit Handicap
- Studieren mit Familie
- Informationen für Schulen
- Auslandsaufenthalt
-
Bewerbung
- Auswahlgrenzen und Vergabeverfahren (NC)
- Bewerbungsportal
- Bewerbung Schritt für Schritt: Von der Bewerbung bis zur Einschreibung
- Bewerbung für ein höheres Fachsemester
- Bewerbung mit beruflicher Qualifikation
- Jungstudierende
- Gasthörerschaft und Zweithörerschaft
- Kontakt Studierendenservice
- Losverfahren
- Promotion
- Sonderanträge
- Studiengang wählen
- Wer kann an der HSBI studieren?
- Studienstart
-
Studium organisieren
- Studierendenservice
- Abschlussunterlagen
- Anerkennung von Leistungen
- Anträge einreichen
- Beurlaubung
- CampusCard
- Einreichung schriftliche Arbeiten
- Erstattung
- Exmatrikulation
- IT-Services
- Online-Serviceportale (LSF/CAT)
- Prüfungsangelegenheiten: Ordnungen, Modulhandbücher
- Rücktritt von einer Modulprüfung
- Rückmeldung
- Semesterbeitrag
- Semesterticket (Deutschlandsemesterticket)
- Semester-, Vorlesungs- und Prüfungszeiten
- Studienbezogene Auslandserfahrung
- Vorlesungsverzeichnis
- Rund ums Studium
- Fachbereiche
- ×
- Forschung
- Transfer
- Weiterbildung
- Internationales
- Karriere an der HSBI
Informationen für gefährdete Wissenschaftler*innen
Foto: Patrick Pollmeier / HSBI
Als Mitglied des internationalen Netzwerks „Scholars at Risk“ zeigt sich die HSBI solidarisch mit gefährdeten Wissenschaftler*innen. Wenn Sie zu dieser Gruppe gehören, finden Sie hier passende Beratungsangebote und Services des Welcome Centers.
Um persönliche Unterstützung zu erhalten, melden Sie sich gerne per E-mail an welcome@hsbi.de bei uns.
Forschungs- und Fördermöglichkeiten an der HSBI
Um als gefährdete*r Wissenschaftler*in an die HSBI kommen zu können, können Sie sich entweder auf eine der regulären Stellenausschreibungen bewerben oder mit Hilfe eines Stipendiums Ihren Aufenthalt an der HSBI finanzieren. Hier sind einige Stipendien, die explizit gefährdete Wissenschaftler*innen unterstützen:
-
Philipp Schwartz-Initiative | Alexander von Humboldt Stiftung
- Zielgruppe: gefährdete Wissenschaftler*innen aus Nicht-EU-Staaten
- Förderung: Stipendium oder Arbeitsvertrag sowie Pauschale für die aufnehmende Einrichtung
- Laufzeit: 24 Monate (ggf. Verlängerung um 12 Monate)
- Antragstellung: über die nominierende Hochschule, eine Gefährdungsbescheinigung ist nötig und muss frühzeit von Ihnen angefordert werden, beispielsweise bei Scholars at Risk
-
Hilde Domin-Programm | DAAD
- Zielgruppe: gefährdete Doktorand*innen
- Förderung: Stipendium, Versicherungen, Reisekostenzuschüsse
- Laufzeit: bis zu 4 Jahre
- Antragstellung: Nominierung durch die aufnehmende Einrichtung, danach Online-Bewerbung durch die nominierte Person
-
Weitere Stipendien (nicht nur für gefährdete Wissenschaftler*innen)
Suche nach Betreuer*innen an der HSBI
Wenn Sie an die HSBI kommen wollen, muss Sie ein*e Gastgeber*in einladen. Wenn Sie noch keine*n Gastgeber*in haben, können Sie sich über unsere Fachbereiche, Forschungsinstitute und aktuellen Forschungsprojekte informieren und hier eventuell eine passende Person finden.
Wenn Sie Unterstützung bei der Suche nach einer Betreuungsperson wünschen, schicken Sie uns gern eine Beschreibung Ihres Lehr- oder Forschungsschwerpunkts an welcome@hsbi.de und wir helfen Ihnen.
Planung und Durchführung Ihres Aufenthalts
Sobald Sie ein Stipendium oder eine reguläre Stelle bekommen und eine*n Betreuer*in an der HSBI gefunden haben, sollten Sie Ihren Aufenthalt vorbereiten. Detaillierte Informationen dazu finden Sie hier.
Wenn für Sie kein Aufenthalt an der HSBI in Frage kommt, weil zum Beispiel Ihr Lehr- und Forschungsbereich bei uns nicht vertreten ist, unterstützen wir Sie gern dabei, eine passende Institution zu finden. Eine Übersicht, welche Fächer an welchen deutschen Hochschulen angeboten werden, bieten der Hochschulkompass und My Guide.
